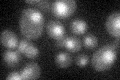
YLR016C
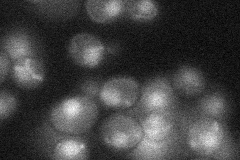
YLR016C
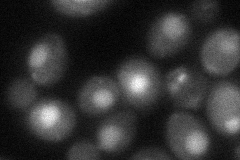
YLR016C

View description
Subunit of the RES complex, which is required for nuclear retention of unspliced pre-mRNAs; acts in the same pathway as Pml39p and Mlp1p
Localization:
Intensity:
Fold change:
Significance:
-
C’ GFP library in SD
nucleus22.04 -
N' NOP1pr-GFP in SD

nucleus74.7683 -
N' TEF2pr-mCherry in SD

nucleus136.494 -
N' NATIVEpr-GFP in SD
nucleus25.0562 -
N' TEF2pr-VC and Cyto-VN in SD
nucleus44.4569 -
C’ GFP library in SD+DTT

nucleus23.231.05No -
C’ GFP library in SD+H2O2

nucleus17.690.8Yes -
C’ GFP library in Starvation Media

nucleus20.890.94No -
C’ GFP library on the background of Pup2-DaMP

nucleus -
C’ GFP library on the background of CCT mutant

nucleus23.13751.04889No
